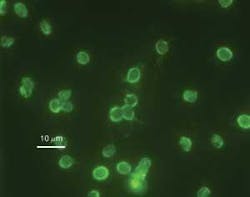
Th Uv Minimises Risk 01 Th Uv Minimises Risk 01

UV Minimises risk from Cryptosporidium
By Tony Leigh
While not completely eliminating a need for residual chemical disinfection, UV light allows for added assurance of drinking water’s safety after series of UK outbreaks.
Ultraviolet (UV) light is increasingly being used as an effective barrier for Cryptosporidium and other emerging (chlorine resistant) organisms in the United Kingdom. Many water companies are now using this technology to ensure water leaving the treatment plant doesn’t pose a risk to health. This article examines the history of UV disinfection, reviews a number of Cryptosporidium outbreaks in the UK, and illustrates some of the advances now being made in the design of UV technology, including use of computational fluid dynamics (CFD) and validation of system performance to enhance its effectiveness.
Some History
In 1801, UV light was discovered by Johann Ritter, who was able to decompose silver chloride using light beyond the violet part of the visible spectrum. The germicidal properties of UV were recognized in 1904 with the award of the Nobel Prize in Physiology to Niels Finsen for his work in treating Lupus vulgaris (skin tuberculosis). And, by 1910, a drinking water facility using a crude UV lamp system was commissioned in Marseilles, France. Early experiences of UV for water disinfection were poor, and the technology wasn’t considered successful. But after the war years, advances in lamp design enabled a number of process industries such as breweries, pharmaceutical plants and fish farms to adopt the technology as a chemical free method of disinfecting process or product water.
Municipal use of UV in drinking water plants was limited to those facilities that used their discharge main for chlorine contact, or in uplands areas where organic loads were high. Population growth, particularly in urban areas led to the consumer being physically closer to the drinking water plant, and so UV systems were installed to provide immediate disinfection. Chlorine remains the primary disinfectant, and is used to ensure that water throughout the distribution system remains free from infection.
The ability of Cryptosporidium to survive outside a host for extended periods in the spore phase (oocyst), coupled with its marked resistance to conventional disinfection such as chlorination has led to UV systems being installed specifically to mitigate against such threats. The outbreak in Clitheroe, Lancashire, in 2000 caused 58 reported cases of diarrhea. In August 2002, Glasgow, Scotland, experienced flooding and 140,000 people received boil water notices following detection of the organism in drinking water. In 2005, the Island of Anglesey in Wales had an outbreak with 1,000 residents contracting cryptosporidiosis. Outbreaks continued in 2007 in Galway, Ireland, and Catterick Garrison, North Yorkshire. In early 2008, an outbreak re-occurred in North Wales, with 45,000 people given boil notices. And, in June, Anglian Water detected the parasite at the Pitsford Water Treatment Works, serving 250,000 people in the county of Northamptonshire.
Outbreaks of Cryptosporidium infestation are often associated with either failure (or absence) of a coagulation-filtration process, and usually absence of UV as a treatment option. So it would seem a prudent investment that UV be considered for high risk drinking water facilities, such as surface water plants, those close to livestock, or those susceptible from agriculture runoff or flooding.
The UK Water Supply (Water Quality) Regulations were introduced in 2000 to implement the European Drinking Water Directive. They set out requirements for monitoring, treatment and analysis of water supplied to consumers, and establish instructions for the continuous monitoring of Cryptosporidium in drinking water. Membranes can physically remove the oocysts from the water, but with a significant capital cost and operating cost burden. Monitoring and not universally treating is a detection rather than prevention approach; the growing scarcity of water and need to conserve and indeed to re-use wastewater for irrigation for example will lead to prevention rather than mere detection.
How UV Works?
UV has the ability to destroy the DNA contained in the nucleus of all living organisms. When properly applied, UV light at wavelengths close to 260 nm is absorbed by the DNA and permanent damage is caused. Once exposed to UV light, the DNA quickly stops normal cell functions, rendering the organism non-viable. Replication is prevented and the organism quickly dies. No species have demonstrated an ability to become resistant to UV, unlike chemical disinfectants where a growing number of organisms have become increasingly tolerant.
Sizing of a UV system is affected by three variables: flow rate, lamp power and transmittance of the light in the water. The leading UV companies, such as atg UV Technology and Trojan Technologies, have developed sophisticated CFD models as accurate predictors of a UV system performance.
The flow profile is produced from the chamber geometry, flow rate and particular turbulence model selected. The radiation profile is developed from inputs such as water quality, lamp type (power, germicidal efficiency, spectral output, arc length) and the transmittance and dimension of the quartz sleeve. Proprietary CFD software simulates both the flow and radiation profiles. Once the 3-D model of the chamber is built, it’s populated with a grid or mesh that comprises thousands of small cubes. Points of interest — such as at a bend, on the quartz sleeve surface, or around the wiper mechanism — use a higher resolution mesh, whilst other areas within the reactor use a coarse mesh. Once the mesh is produced, hundreds of thousands of virtual particles are “fired” through the chamber. Each particle has several variables of interest associated with it, and the particles are “harvested” after the reactor. Discrete phase modeling produces delivered dose, headloss and other chamber specific parameters.
When the modeling phase is complete, selected systems are validated using a professional third party to provide oversight and to determine how closely the model is able to predict the reality of system performance. System validation uses non-pathogenic surrogates to determine the Reduction Equivalent Dose (RED) ability of the reactors. Most systems are validated to deliver 40 mJ/cm2 within an envelope of flow and transmittance. To validate effectiveness, Ultraviolet Absorption Method 5910 B-00 is the standard method used by the U.S. Environmental Protection Agency, whilst Europe is adopting this alongside Germany’s DVGW 294 standard. The models are then used to guide installation, and show the detrimental effect of locating a bend or valve on fluid flow patterns.
A UK Case Study
In June 2008, a rabbit got into the wash water tank at the Pitsford Drinking Water Plant of Anglian Water, leading to contamination of the treatment works with Cryptosporidium The parasite was detected on June 24 and, following consultation with health and local authorities, a notice to boil drinking water was issued for more than 100,000 households served by the plant. With 22 people sickened by the outbreak, about 500,000 litres of bottled water were handed out as well. A quick decision to deploy UV led to seven systems — including two validated UV systems from ATG — being installed by the end of the weekend. A week after the initial discovery, all water being produced was free from Cryptosporidium
The UV sleeves are automatically wiped to maintain the optical path and ensure uniform disinfection. Lamps can be changed while the system is online and output is monitored using a specifially designed UV monitor camera. UV lamp power is adjusted automatically to ensure the correct UV dose is delivered to the water.
The UV systems are installed in-line into a 24-inch main. The design avoids bends that would be detrimental to system performance. The units are capable of being controlled locally or remotely by SCADA. The system adjusts automatically for lamp ageing and changes in water transmittance to deliver a constant UV dose.
Author’s Note:
Tony Leigh is technical director atg UV Technology, of Pemberton, Wigan, UK. The company was founded as Willand UV System in 1981 and has performance validated systems for a number of UV systems installed globally as a disinfection barrier. Contact: +44 (0) 1942 216161, [email protected] or www.atguv.com